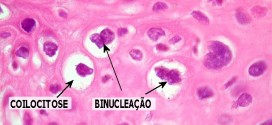

Los tumores malignos de las vías biliares. La vesícula se localiza en la fosa vesicular, en la cara inferior del hígado. Por lo general su localización es extrahepática. Mide de 7 a 10 centímetros de largo por 3 centímetros de transverso en su cuerpo. El cuerpo vesicular se continúa con el cuello que termina en la ampolla y luego se continúa con un conducto denominado …
Leer MásEnfermedades
NEOPLASIA DE ÚTERO
La neoplasia de útero. Los virus del papiloma humano (VPH) de los tipos 16 y 18 son los principales tipos que se asocian al cáncer ginecológico y genital. A saber, sin olvidar a los demás. Tumor maligno casi siempre y especialmente el formado por células epiteliales. Los canceres en grupos o categorías como el carcinoma, sarcoma, adenosarcoma, neoplasias, etc. La …
Leer MásMELASMA o MELAS
La melasma o melas. El Melasma (o Cloasma) es aquella pigmentación de color marrón que aparece de forma difusa en el labio superior, las mejillas, la frente. Se presenta como máculas (manchas) simétricas e hiperpigmentada y de borde irregular. Ocurre sobre todo en mujeres a consecuencia de la exposición solar unida en ocasiones a la toma de anticonceptivos orales o …
Leer MásLEUCOPLASIA MALIGNA DEL GLANDE
La leucoplasia maligna del glande. Es un Proceso Irritativo Benigno que consiste en numerosas placas blanquecinas (10 – 12mm), no dolorosas, las que asientan sobre el prepucio o en el glande, por lo que frecuentemente afectan al meato. Histológicamente se trata de una Hiperplasia del Estrato Espinoso de la piel y/o de una Hipertrofia de las Glándulas Dérmicas que pueden …
Leer MásEPITELIOMA BASOCELULAR DEL OIDO.
El epitelioma basocelular del oído. Durante los primeros años de vida de una persona, las células normales se dividen más rápidamente para permitir el crecimiento. El cuerpo está compuesto por billones de células vivas. Las células normales del cuerpo crecen, se dividen formando nuevas células y mueren de manera ordenada. Una vez que se llega a la edad adulta, la …
Leer MásCISTOADENOCARCINOMA OVÁRICO
El cistoadenocarcinoma ovárico. El ovario puede definirse como la glándula sexual femenina que en número par y forma ovoidea, se sitúa a cada lado del útero y sobre la vertiente posterior de los ligamentos anchos. Consta de una porción central, sustancia medular o bulbo, fibrovascular que contiene los folículos y estructuras afines y una porción cortical, túnica albugínea, membrana germinativa …
Leer MásCARCINOMAS MALIGNOS DE LAS VÍAS URINARIAS
Los carcinomas malignos de las vías urinarias. Durante los primeros años de vida de una persona, las células normales se dividen más rápidamente para permitir el crecimiento. El cuerpo está compuesto por billones de células vivas. Las células normales del cuerpo crecen, se dividen formando nuevas células y mueren de manera ordenada. Una vez que se llega a la edad …
Leer MásCARCINOMA PULMONAR DEL LÓBULO SUPERIOR DERECHO
El carcinoma pulmonar del lóbulo superior derecho. Durante los primeros años de vida de una persona, las células normales se dividen más rápidamente para permitir el crecimiento. El cuerpo está compuesto por billones de células vivas. Las células normales del cuerpo crecen, se dividen formando nuevas células y mueren de manera ordenada. Una vez que se llega a la edad …
Leer MásCARCINOMA PAPILAR INFILTRANTE DE MAMA
El carcinoma papilar infiltrante de mama. Durante los primeros años de vida de una persona, las células normales se dividen más rápidamente para permitir el crecimiento. El cuerpo está compuesto por billones de células vivas. Las células normales del cuerpo crecen, se dividen formando nuevas células y mueren de manera ordenada. Una vez que se llega a la edad adulta, …
Leer MásCARCINOMA PAPILAR DEL EPITELIO RESPIRATORIO
El carcinoma papilar del epitelio respiratorio. Durante los primeros años de vida de una persona, las células normales se dividen más rápidamente para permitir el crecimiento. El cuerpo está compuesto por billones de células vivas. Las células normales del cuerpo crecen, se dividen formando nuevas células y mueren de manera ordenada. Una vez que se llega a la edad adulta, …
Leer MásCONDILOMA PLANO
El condiloma plano. Son condilomas sifilíticos, planos y anchos, a menudo secretantes, de la región anogenita. Placa mucosa. Lesión luética que aparece durante el período secundario de la sífilis. Se presenta como una excrecencia aplanada, blanca, húmeda y contiene una gran cantidad de espiroquetas; es muy contagiosa. Las lesiones presentes en esta etapa de la enfermedad se denominan sifílides y …
Leer MásCOMEDÓN
El comedón. La epidermis (capa superficial de la piel) se diseminan gran cantidad de poros, es decir, pequeñísimos orificios a través de los cuales se excretan cabello y grasa (producida por las glándulas sebáceas, la cual se conoce como sebo), cuya finalidad es proteger a la piel, así como sudor, que ayuda a regular la temperatura corporal. En zonas del …
Leer MásCISTOADENOMA SEROSO OVÁRICO
El cistoadenoma seroso ovárico. Ver cáncer de ovario.
Leer MásCARCINOMA MALIGNO RENAL
El carcinoma maligno renal. Tumor maligno en general y especialmente el formado por células epiteliales. El cáncer de riñón ocupa el tercer lugar en frecuencia de los tumores urológicos y representa el 3 por ciento de todos los tumores del organismo. Los riñones son dos órganos de color marrón rojizo con forma de poroto, cada uno de los cuales tiene …
Leer MásCARCINOMA MALIGNO INTRAHEPÁTICO
El carcinoma maligno intrahepático. Tumor maligno en general y especialmente el formado por células epiteliales. Durante los primeros años de vida de una persona, las células normales se dividen más rápidamente para permitir el crecimiento. El cuerpo está compuesto por billones de células vivas. Las células normales del cuerpo crecen, se dividen formando nuevas células y mueren de manera ordenada. …
Leer MásCARCINOMA LOBULAR MALIGNO DE MAMA
El carcinoma lobular maligno de mama. Las mamas o senos se componen de grasa, tejido conectivo y glandular. En este tejido se encuentran las glándulas productoras de leche de las que nacen unos 15 ó 20 conductos mamarios, para transportar la leche hasta el pezón, rodeado por la areola. Estos lobulillos y conductos se encuentran en el estroma, un tejido …
Leer MásCARCINOMA DE CÉLULAS DEL EPITELIO DE LAS VÍAS BILIARES
El carcinoma de células del epitelio de las vías biliares. Es una enfermedad por la cual se forman células malignas cancerosas en los tejidos de la vesícula biliar es una enfermedad poco frecuente por la que se encuentran células cancerosas en los tejidos de la vesícula biliar. Tumor maligno en general y especialmente el formado por células epiteliales, a saber. …
Leer MásAMIMIA RECEPTIVA
La amimia receptiva. Trastornos en la comprensión de los gestos o signos debido a la amnesia de los mismos. Afección del sistema nervioso central, cerebral, etc, de probable patogenia autoinmune, etc, que se caracteriza por placas de desmielinizacion seguidas de esclerosis (endurecimiento o induración morbosa de los tejidos), localizadas en la sustancia blanca del encéfalo y médula. De curso crónico, …
Leer MásTUMORES DUODENALES
Los tumores duodenales. Tumores malignos en general y especialmente el formado por células epiteliales. Los tumores duodenales constituyó el 1,6% de las neoplasias malignas gastrointestinales, siendo la correlación endoscópica e histológica de 86,2%. La edad promedio fue de 64,9 años, con predominio del sexo masculino (64%). En los últimos años la incidencia de estos tumores ha presentado un discreto aumento, …
Leer MásTUMORES MALIGNOS DE PRÓSTATA
Los tumores malignos de próstata. Publicado en: binipatia.com Escrito por: Salvador Gregori y Abby Schaffner Etiquetas: sustancias súper nutritivas, tratamiento natural, reishi, vitamina D3 Resumiendo: La próstata es un órgano del sistema reproductor del varón. Es una glándula, con forma de castaña, colocada debajo de la vejiga y por delante del recto. La uretra (conducto por donde sale la orina) atraviesa la …
Leer Más Binipatia e higienismo Medicina natural alternativa, plantas medicinales y remedios caseros naturales
Binipatia e higienismo Medicina natural alternativa, plantas medicinales y remedios caseros naturales